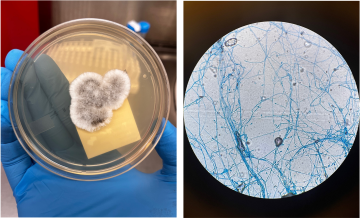
Gloved hand holds a petri dish with mold growth, alongside a microscope view of blue-stained fungal hyphae.

About Transplant Infectious Disease
Welcome from our director

It is our great pleasure to welcome you to the world of transplant infectious disease (TID) at UCLA Health.
As a tertiary care center, UCLA provides ample clinical and research opportunities for TID fellowship. We ensure that our fellows experience an interactive and informative journey throughout their year of training. Our staff is dedicated to excellent patient care, mentorship and teaching.
The TID fellowship is a close-knit, yet diverse program designed to train independent clinicians to handle challenging clinical situations in transplant infectious diseases. We value diversity and equity and encourage creative ideas that will help improve our training program. We hope you appreciate our values in the TID fellowship program at UCLA and enjoy learning about the experiences of our current and past fellows.
Connect with me on Bluesky: @jschaenmanmd.bsky.social
Apply to the TID Fellowship
Applicants should submit a one-page personal statement, cover letter, and three letters of recommendation. For all incoming applications, please apply here.
For questions please contact Dr. Joanna Schaenman: [email protected]
Our mission
Our mission is to bring together members of different specialties within the field of transplant, which will allow us to better care for patients. We want to provide a platform where a diverse group of trainees can prosper and add their unique, valuable skills to the field of transplant infectious diseases. We hope to inspire clinicians to have an innovative approach to this evolving field and raise awareness of transplant infectious diseases.
Why TID at UCLA Health?
Ronald Reagan UCLA Medical Center is a solid organ transplantation program with some of the highest volumes in the country. More than 600 transplants were performed in 2017, including over 120 thoracic organ transplants. At UCLA Health, we work closely with pharmacists, nurses, the microbiology department, house staff, and other departments to bring the best service to our patients. This provides a unique experience for our fellows — it means they can learn from the best of the experiences.
Due to an increase in awareness and growth in solid organ and stem cell transplant programs, TID has gained more popularity and respect. Research and innovation allow us to increase survival among transplant recipients, and pre- and post-transplant protocols help to improve safety after transplantation. Despite this, we still face many challenges in managing donor and recipient infections.
Immunocompromised patients with simple infections like respiratory syncytial virus (RSV), cytomegalovirus (CMV), and others have an increased risk of mortality and morbidity compared to the average person. Potentially life-threatening infections among immunosuppressed patients require a delicate balance of immunosuppressive and antimicrobial agents. There is also a shift in epidemiology of certain infections, causing an increase in opportunistic infections and epidemics. The challenges have only grown after the beginning of SARS-COV2 pandemic, putting immunocompromised individuals at further risk of infection.
While relatively early in its development, we can only expect TID to grow in the coming years due to changing epidemiology of the disease and increases in bacterial, viral and fungal resistance.
The need for TID experts
The field of transplant infectious diseases is practiced around the world, and the need for experts trained in this area grows each year. The growth of TID is needed to meet the expanding needs of solid organ and stem cell transplantation, where patients are increasingly older and more medically complex compared to years past. Physicians must be aware of the needs of patients and work closely with them.
Transplantation provides a second chance to many of our candidates, but physicians should be aware of environmental, epidemiologic, opportunistic and other factors leading to infections in transplant patients. This specialty develops appropriate pre-transplant and post-transplant guidelines to improve clinical outcomes and quality of life in transplant patients.